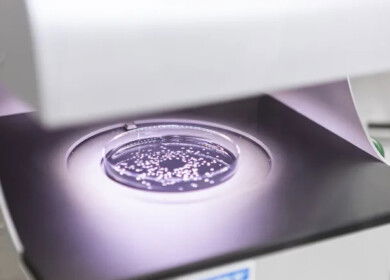
Syngenta and Amoéba partner to launch in Europe new bio-fungicide for wheat and field crops by 2026

Koppert and Amoéba sign five-year distribution deal for novel biofungicide

Koppert, a Netherlands-based leader in biological crop protection, and French greentech firm Amoéba have entered into a five-year commercial agreement to distribute a new biofungicide developed by Amoéba. The deal, signed on June 3, 2025, grants Koppert exclusive distribution rights across 18 European countries and the United States, with a targeted market launch in early 2026.
The biofungicide, derived from the lysate of the amoeba Willaertia magna C2c Maky, is designed to protect crops such as grapevines, potatoes, and tomatoes from fungal diseases including downy mildew and late blight. It functions through a dual mode of action: stimulating the plant’s natural defenses and directly inhibiting pathogen development. The product has received approval as a biocontrol active substance from the European Commission, following a favorable assessment by the European Food Safety Authority (EFSA).
Under the agreement, Koppert will distribute the biofungicide under its own brand name in countries including France, Germany, Italy, Spain, and the Netherlands, as well as in the US. The companies are also exploring potential market entry in Brazil.
“This agreement marks a significant step forward in expanding our portfolio of innovative biological solutions,” said Martin Koppert, Chief Business Officer of Koppert. “It aligns perfectly with our mission to support growers with sustainable and effective crop protection tools.”
Jean-François Doucet, CEO of Amoéba, described the agreement as a pivotal moment for the company. “The signing of this commercial agreement with the world leader in biocontrol is a key milestone,” he said. “It confirms the strong potential of our biofungicide and paves the way for its successful market introduction.”
The companies plan to collaborate on the co-development of additional biological solutions, leveraging their combined expertise in sustainable agriculture. They will also evaluate production logistics and scale-up strategies based on future operational feedback.
Amoéba, founded in 2010 and based in Chassieu, France, focuses on biological solutions for environmental and agricultural applications. The company is listed on Euronext Growth Paris under the ticker AMEBA.

Enjoyed this story?
Every Monday, our subscribers get their hands on a digest of the most trending agriculture news. You can join them too!

Discussion0 comments